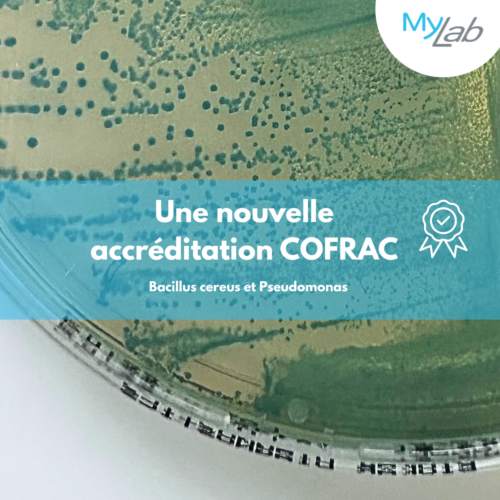

Actualité
- Retrouver toutes les actualités du laboratoire MyLab
Une nouvelle accréditation COFRAC
Nous vous informons de l’extension de la portée de l’accréditation COFRAC du laboratoire MyLab. Nous sommes désormais accrédités sur les analyses microbiologiques des bactéries Bacillus cereus et Pseudomonas sur les produits alimentaires (Bacillus cereus méthode NF EN ISO 7932 et BKR 23/06-02/10 et Pseudomonas spp XP ISO/TS 11059 et BKR 23/09-05/15 B).
Cette nouvelle accréditation vient s’ajouter à celle déjà en vigueur :
- LAB GTA 05 Physico-chimie des eaux
- LAB GTA 25-61 Physico-chimie du lait
- LAB GTA 59 Microbiologie des aliments
- LAB REF 15 (Paiement du lait 3 espèces)
- LAB GTA 27 (Santé animale)
- LAB GTA 26 (Physico-chimie / divers aliments)
Notre attestation est téléchargeable en cliquant ici. Vous pouvez également retrouver notre portée d’accréditation sur le site du Cofrac.
Cette accréditation atteste de la qualité, de la fiabilité et de la rigueur de nos analyses 🔬🧪, ainsi que de notre engagement constant à répondre aux exigences les plus élevées du secteur. Mais c’est aussi une preuve de confiance pour nos partenaires et clients
Mise à jour de notre index égalité homme femme


